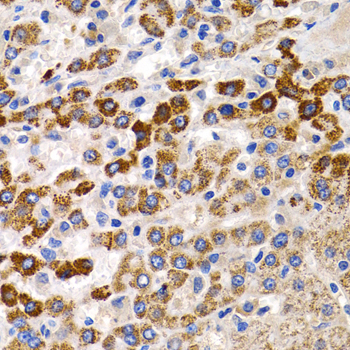
A1805: image 5
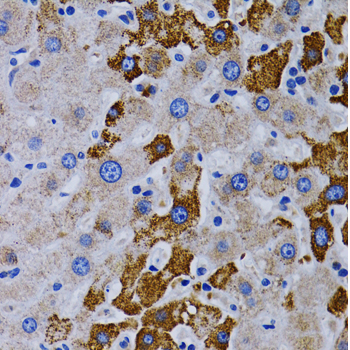
A1805: image 6

For quotations, please use our online quotation form, and you may also contact us by
sales@neoscientific.com
+1-888.733.6849
+1-617.299.7367 (Int’l)
+1-888.733.6849
+1-617.299.7367 (Int’l)
| Reactivity | Human Mouse Rat |
| Tested applications | WB IHC |
| Recommended Dilution | WB 1:500 - 1:2000 IHC 1:50 - 1:200 |
| Calculated MW | 59kDa |
| Observed MW | Refer to figures |
| Immunogen | Recombinant protein of human CYP24A1 |
| Storage Buffer | Store at -20℃. Avoid freeze / thaw cycles. Buffer: PBS with 0.02% sodium azide, 50% glycerol, pH7.3. |
| Synonym | CP24; HCAI; CYP24; P450-CC24; |

Western blot analysis of extracts of various cells, using CYP24A1 antibody.

Immunohistochemistry of paraffin-embedded rat lung using CYP24A1 antibody at dilution of 1:200 (400x lens).

Immunohistochemistry of paraffin-embedded rat kidney using CYP24A1 antibody at dilution of 1:200 (400x lens).

Immunohistochemistry of paraffin-embedded rat pancreas using CYP24A1 antibody at dilution of 1:200 (400x lens).
Immunohistochemistry of paraffin-embedded mouse kidney using CYP24A1 antibody at dilution of 1:200 (400x lens).
Immunohistochemistry of paraffin-embedded human liver cancer using CYP24A1 antibody at dilution of 1:200 (400x lens).

Immunohistochemistry of paraffin-embedded human liver cancer using CYP24A1 antibody at dilution of 1:200 (400x lens).
This gene encodes a member of the cytochrome P450 superfamily of enzymes. The cytochrome P450 proteins are monooxygenases which catalyze many reactions involved in drug metabolism and synthesis of cholesterol, steroids and other lipids. This mitochondrial protein initiates the degradation of 1,25-dihydroxyvitamin D3, the physiologically active form of vitamin D3, by hydroxylation of the side chain. In regulating the level of vitamin D3, this enzyme plays a role in calcium homeostasis and the vitamin D endocrine system. Alternatively spliced transcript variants encoding different isoforms have been found for this gene.
N/A